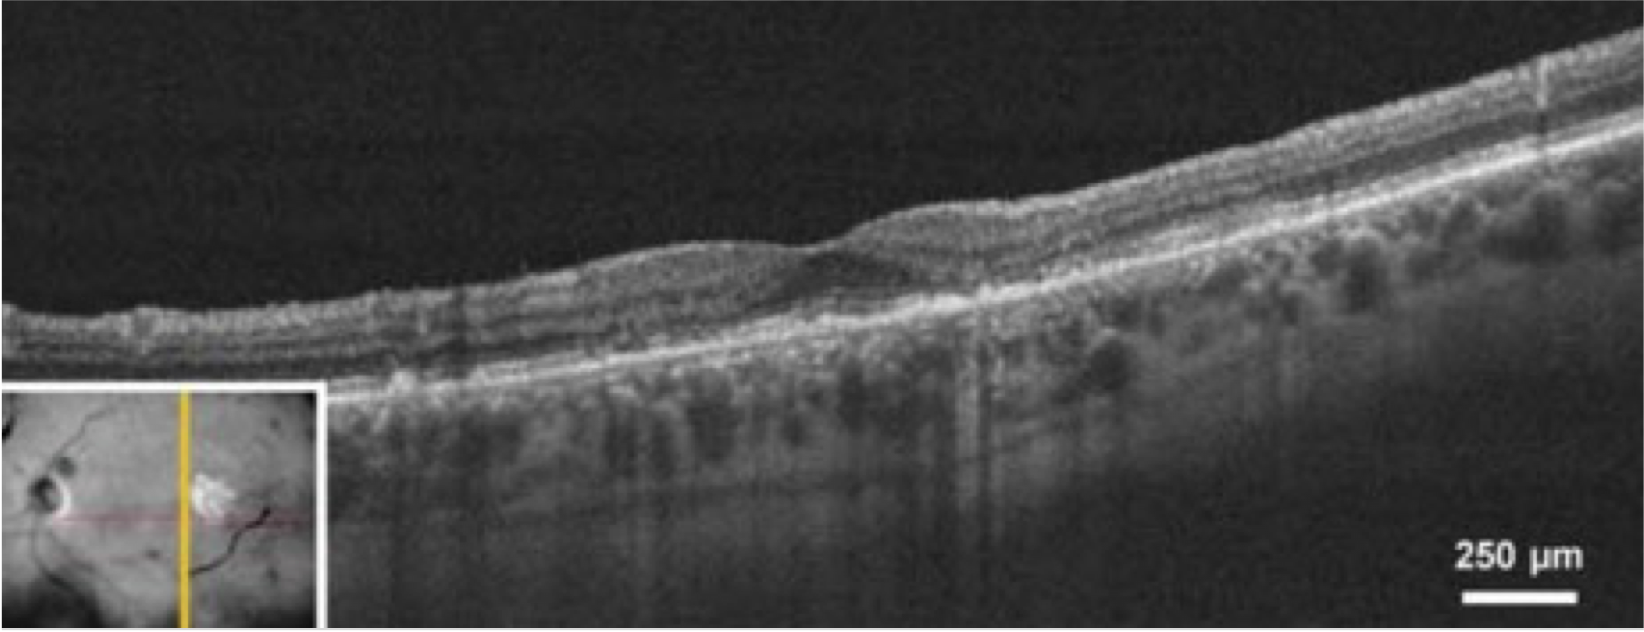
dryAMD.eu Imagen de tomografía de coherencia óptica (TCO) de un ojo en un paciente con atrofia geográfica.10

DIAGNÓSTICO Y SEGUIMIENTO DE LA DMAE
¿Qué es un diagnóstico?
El término diagnóstico es definido por el Diccionario Merriam-Webster como "el arte o acto de identificar una enfermedad por sus signos y síntomas".
En lo que respecta a la degeneración macular asociada a la edad (DMAE), significa que un profesional sanitario, como un oftalmólogo o un optometrista, realiza una serie de pruebas y exámenes para determinar si un paciente puede tener DMAE.2 Estas técnicas se centran en la función visual, así como en técnicas de imagen para visualizar la retina y la mácula en el fondo del ojo. Aquí le presentamos las diferentes técnicas de diagnóstico relacionadas con la DMAE.
La única forma de diagnosticar la DMAE es someterse a un examen ocular completo, que incluya una revisión de la mácula, por parte de un optometrista o un oftalmólogo.
Hay que tener en cuenta que muchas de estas técnicas también se utilizan para monitorizar a un paciente a lo largo del tiempo después de que se le haya diagnosticado la DMAE. Su profesional sanitario le indicará la frecuencia con la que debe acudir a las visitas de seguimiento, y es importante que siga sus consejos.
Controlar su propia visión.
Si le han diagnosticado DMAE o tiene riesgo de desarrollar una enfermedad ocular, es importante que se asegure de vigilar cualquier cambio en su visión.
La rejilla de Amsler es una herramienta de autocomprobación esencial1 y fácil de usar que sirve para detectar cambios tempranos en su visión. Estos cambios pueden incluir distorsión (líneas rectas que aparecen onduladas), manchas borrosas u oscuras.
Es importante no confiar en la rejilla de Amsler para el diagnóstico, ya que no puede sustituir a los exámenes oculares regulares. La única forma de diagnosticar la DMAE es someterse a un examen ocular, que incluya una revisión de la mácula, por parte de un optometrista u oftalmólogo. Tenga en cuenta que los cambios en la visión en una cuadrícula de Amsler también pueden ser un signo de otra enfermedad ocular distinta a la DMAE.

Si detecta cualquier cambio en su visión, es importante que consulte a un optometrista u oftalmólogo lo antes posible.

Puede descargar e imprimir una cuadrícula de Amsler haciendo clic en el siguiente enlace o visitando la sección de "herramientas de apoyo" del sitio web. La descarga incluye una cuadrícula de Amsler, así como instrucciones paso a paso sobre cómo utilizarla para monitorizar su propia visión.
La única forma de diagnosticar la DMAE es someterse a un examen ocular completo, que incluya una revisión de la mácula, por parte de un optometrista o un oftalmólogo.
En el siguiente apartado se ofrece una visión general de los exámenes que pueden realizarse.
Pruebas utilizadas para diagnosticar y controlar la Degeneración Macular Asociada a la Edad (DMAE)
Exámenes oculares realizados por optometristas u oftalmólogos.
La única forma de diagnosticar la DMAE es someterse a un examen ocular completo que incluya una revisión de la mácula, realizado por un optometrista u oftalmólogo.2 En el siguiente apartado se ofrece un resumen de los exámenes que pueden realizarse. Tenga en cuenta que su profesional sanitario no llevará a cabo todas las pruebas y que las pruebas realizadas pueden variar según la zona geográfica. Si tiene alguna duda relacionada con alguna de las pruebas, debe preguntar a su profesional sanitario en su próxima visita.
En general, las pruebas más comunes utilizadas en el diagnóstico y seguimiento de la DMAE son las siguientes:
• Examen ocular completo
• Examen del fondo de ojo
• Oftalmoscopia
• Fotografía del fondo del ojo
• Tomografía de coherencia óptica (TCO)
• Angiografía de fondo de ojo con fluoresceína
• Autofluorescencia del fondo de ojo
Las pruebas menos comunes utilizadas en el diagnóstico y seguimiento de la DMAE son las siguientes:
• Angiografía con verde de indocianina
• Microperimetría
• Agudeza visual con baja luminosidad
• La tabla de agudeza de MNRead
• Examen de sensibilidad al contraste
• El Índice de Independencia Funcional de la Lectura
En la siguiente sección encontrará una descripción más detallada de las pruebas mencionadas.
Pruebas utilizadas para diagnosticar y controlar la Degeneración Macular Asociada a la Edad (DMAE)
Examen ocular completo
El principal síntoma que experimentan las personas con DMAE es la pérdida de visión. Por lo tanto, la DMAE suele diagnosticarse mediante un examen ocular rutinario. Un examen completo de agudeza visual mide la capacidad de una persona para ver detalles, formas y letras a una determinada distancia.3 La agudeza visual mejor corregida se evalúa normalmente utilizando una tabla de Snellen, pero tenga en cuenta que su profesional sanitario también puede utilizar otras tablas. El número de letras que una persona puede identificar correctamente representa su agudeza visual. Dicho de otro modo, cuanto más abajo en la tabla de Snellen pueda leer una persona, mejor será su agudeza visual.3

Examen del fondo de ojo
El examen del fondo de ojo es una prueba más exhaustiva para ayudar a diagnosticar la DMAE. Se trata de un examen óptico de la retina en la parte posterior del ojo. Tenga en cuenta que «fondo de ojo» no es más que un término médico para designar la parte de un órgano que está más alejada de la abertura, y en este caso, se refiere a la parte posterior del ojo. El examen del fondo de ojo puede realizarse mediante oftalmoscopia o fotografía del fondo de ojo.2 En ambos métodos, se aplican gotas dilatadoras en el ojo del paciente para que el profesional pueda ver mejor la parte posterior del ojo.4
Oftalmoscopia
En este método de examen ocular, el profesional proyecta una luz brillante a través de la pupila dilatada y un oftalmoscopio proporciona imágenes ampliadas de la retina. La oftalmoscopia es una importante herramienta diagnóstica para la DMAE, ya que permite al profesional ver anomalías de la retina como atrofia, drusas, cambios pigmentarios y neovascularización coroidea (NVC).5,6 Existen tres formas de oftalmoscopia.
Oftalmoscopia directa
En la oftalmoscopia directa, el profesional proyecta una luz brillante a través de la pupila mediante un oftalmoscopio manual.

Oftalmoscopia indirecta
La oftalmoscopia indirecta es el tipo más común de oftalmoscopia.5 En ella, el profesional envía una luz brillante a través de la pupila desde un oftalmoscopio montado en la cabeza y utiliza una lente manual.5

Oftalmoscopia con lámpara de hendidura
Este tipo de examen se utiliza habitualmente para diagnosticar la DMAE y se realiza con un microscopio oftálmico de lámpara de hendidura.5 La barbilla del paciente se apoya en un dispositivo de lámpara de hendidura, la luz se envía a través de una estrecha hendidura al ojo del paciente y el profesional examina el fondo de ojo a través de una lupa.5

Fotografía del fondo de ojo
La fotografía del fondo de ojo se realiza con un microscopio de baja potencia para tomar imágenes en color de la retina.7 Se utiliza habitualmente en el diagnóstico de la DMAE, ya que muestra anomalías de la retina como drusas, anomalías pigmentarias, atrofia, hemorragias y acumulación de líquido.7 Las imágenes tomadas a lo largo del tiempo pueden compararse para monitorizar la evolución de la enfermedad.


Modalidades de imagen y manifestaciones
Hay una serie de técnicas de imagen que proporcionan una visualización más detallada de la retina en personas con DMAE. Estas técnicas permiten a los profesionales evaluar el estadio y la gravedad de la enfermedad en el momento del diagnóstico, así como monitorizar la progresión de la enfermedad a lo largo del tiempo.
Tomografía de coherencia óptica (TCO)
La TCO es una importante técnica de imagen para el diagnóstico y seguimiento de la DMAE. Toma imágenes transversales de la retina y proporciona una evaluación detallada de la salud de la misma. La TCO puede medir el grosor de la retina, identificar las drusas y la neovascularización coroidea, que son características típicas de la DMAE.8,9

Angiografía de fondo de ojo con fluoresceína (AGF)
En la angiografía con fluoresceína, se inyecta por vía intravenosa un colorante fluorescente para obtener imágenes de los vasos sanguíneos de la retina.11 La AGF se utiliza normalmente para excluir el diagnóstico de DMAE húmeda. También puede utilizarse en la DMAE seca o en la atrofia geográfica, ya que las regiones atróficas presentan una mayor fluorescencia debido a la muerte del epitelio pigmentario de la retina (EPR).8

Las imágenes de AGF muestran detalles de la vasculatura de la retina, así como la eliminación del colorante en las partes normales de la retina y la continuidad de la fluorescencia en las zonas con anomalías de la retina.12


Autofluorescencia del fondo de ojo
La autofluorescencia del fondo de ojo es una importante técnica de imagen para el diagnóstico y monitorización de la DMAE, en particular de la DMAE avanzada seca o atrofia geográfica (AG).11 Se utiliza una luz específica (normalmente azul) para producir la autofluorescencia de una molécula llamada lipofuscina, que suele estar distribuida uniformemente por toda la retina.8 Las regiones no sanas de la retina pueden aparecer más oscuras en el caso de las zonas atróficas, o más brillantes en el caso de las drusas, ambos signos de DMAE.8,13 Elpatrón de fluorescencia puede indicar la potencial tasa de progresión de la DMAE de un paciente.14

Angiografía con verde de indocianina (AVIC)
La ICG es una técnica de imagen utilizada para excluir la DMAE húmeda y también para evaluar las lesiones atróficas en la retina de la DMAE seca.13 El concepto de AVIC es como la autofluorescencia del fondo de ojo. También utiliza la luz que se inyecta en la retina para excitar la fluorescencia, aunque la AVIC utiliza un tinte inyectable en el torrente sanguíneo y permite una mejor resolución de la imagen.13

Pruebas funcionales adicionales
Además de las pruebas de visión descritas anteriormente, pueden utilizarse otros exámenes funcionales para controlar la función visual de las personas con DMAE y evaluar el impacto en su vida diaria.
Microperimetría
La microperimetría evalúa la capacidad del ojo para percibir los estímulos luminosos en diferentes partes de la retina. Se trata de un dispositivo de imagen de la retina con una prueba de campo visual en la que se puede mapear espacialmente la función de los fotorreceptores. Los fotorreceptores son las células sensibles a la luz de la retina. En la microperimetría, la retina se expone a pequeños puntos de luz de distintas intensidades. El paciente, al pulsar un botón, confirma haber percibido el estímulo luminoso.15 A continuación, se identifican las posibles pérdidas de campo visual en la retina de la persona.15

Agudeza visual con baja luminosidad (AVBL)
La agudeza visual de las personas con DMAE suele estar reducida en condiciones de poca luz.8 Como su nombre indica, la agudeza visual con baja luminosidad mide la función visual en condiciones de poca luz. De forma similar a la mejor agudeza visual corregida (AVMC), los pacientes ven una tabla optométrica, pero con la LLVA esto se hace a través de filtros que reducen los niveles de luz.16 La diferencia entre la agudeza visual medida con luz normal y la agudeza visual con baja luminosidad se calcula y se identifica como déficit de baja luminosidad.17 El LLD de una persona puede correlacionarse con las lesiones de la DMAE.17 Las personas con estadios tempranos de DMAE tienden a obtener peores resultados en el examen de agudeza visual con baja luminosidad que en el examen AVMC.17

La tabla de agudeza ¨MNRead¨ o tabla de lectura de baja visión de Minnesota
En la vida cotidiana, la variedad de tamaños de los textos puede ser un gran reto para las personas con DMAE, ya que suelen desarrollar dificultades para mantener una buena velocidad de lectura. La tabla de agudeza ¨MNRead¨ mide la velocidad de lectura del individuo en relación con el tamaño de la letra. Una persona lee en voz alta frases en tamaños de letra decrecientes a partir de un gráfico. El punto en el que la velocidad de lectura disminuye con un tamaño de letra menor está correlacionado con su capacidad visual.

Examen de sensibilidad al contraste
El examen de sensibilidad al contraste utiliza la tabla de sensibilidad al contraste de Pelli-Robson. Esta tabla utiliza letras del mismo tamaño que progresan de alto a bajo contraste.18 Cuanto más difícil sea para una persona distinguir las letras, menor será su sensibilidad al contraste. En la DMAE, los exámenes de sensibilidad al contraste ayudan a detectar anomalías visuales que podrían no ser captadas en un examen de agudeza visual.19

El índice de independencia lectora funcional (FRI1)
El índice de independencia lectora funcional es una medida notificada por el paciente que evalúa la capacidad de una persona con DMAE avanzada seca para leer en una variedad de actividades relacionadas con la lectura.20
Los parámetros del índice de independencia lectora funcional incluyen la lectura de las etiquetas de los frascos de medicamentos o las etiquetas de los alimentos, la lectura necesaria para llevar las finanzas y emitir cheques, y la lectura de palabras en un televisor o un ordenador.20 Esta medida es particularmente importante para las personas con DMAE avanzada seca o AG que a menudo pueden tener déficits visuales que no son captados por la agudeza visual mejor corregida.

Recursos y enlaces útiles
Referencias:
- Have AMD? Save Your Sight with an Amsler Grid. Accessed Nov. 15, 2021.
https://www.aao.org/eye-health/tips-prevention/facts-about-amsler-grid-daily-vision-test - Apellis GA Dossier Section 8.3 2.
- Lakshminarayanan, V. Visual acuity. in Handbook of Visual Display Technology vol. 1 93–99 (Springer Berlin Heidelberg, 2012).
- Mitchell P, Liew G, Gopinath B, Wong TY. Age-related macular degeneration. The Lancet. 392(10153):1147-59.
- American Academy of Ophthalmology. What is the difference between direct and indirect ophthalmoscopy? https://www.aao.org/eye-health/ask-ophthalmologist-q/what-is-difference-between-direct-indirect-ophthal. Published September 12, 2016. Accessed August 12, 2020.
- American Academy of Ophthalmology. What is a Slit Lamp? https://www.aao.org/eye-health/treatments/what-is-slit-lamp Published April 23, 2018. Accessed August 12, 2020.
- Townsend WD. Scleral depression. Optom Clin. 1992; 2(3);127-44 (1992).
- Fleckenstein M, Mitchell P, Freund KB. The progression of geographic atrophy secondary to age-related macular degeneration. Ophthalmology. 2018;125:369-90.
- Garcia-Layana A, Ciuffo G, Zarranz-Ventura J, Alvarez-Vidal A. Optical coherence tomography in age-related macular degeneration. www.amdbook.org. https://amdbook.org/content/optical-coherence-tomography-age-related-macular-degeneration. Updated July 2017. Accessed August 12, 2020.]
- Boyer DS, Schmidt-Erfurth U, van Lookeren Campagne M, Henry EC, Brittain C. THE PATHOPHYSIOLOGY OF GEOGRAPHIC ATROPHY SECONDARY TO AGE-RELATED MACULAR DEGENERATION AND THE COMPLEMENT PATHWAY AS A THERAPEUTIC TARGET. Retina. 2017 May;37(5):819-835. doi: 10.1097/IAE.0000000000001392. PMID: 27902638; PMCID: PMC5424580.
- Flaxel CJ, Adelman RA, Bailey ST, et al. AMD preferred practice pattern®. Ophthalmology. 2019.
- Bennett TJ. Interpretation. Ophthalmic Photographers’ Society website. 2019. Accessed September 9, 2020. https://www.opsweb.org/page/FAinterpretation
- Holz FG, Sadda SR, Staurenghi G, et al. Imaging protocols in clinical studies in advanced AMD: recommendations from classification of atrophy consensus meetings. Ophthalmology. 2017;124(4):464-78.
- Holz FG, Bindewald-Wittich A, Fleckenstein M, et al. Progression of geographic atrophy and impact of fundus autofluorescence patterns in AMD. Am J Ophthalmol. 2007;143(3):463-72.
- Csaky, K. G. et al. Microperimetry for geographic atrophy secondary to AMD. Surv. Ophthalmol. 2019;64, 353-64. 2. Apellis doc. Modules Conent_Modules 6 Conent d3.
- Sadda SR, Chakravarthy U, Birch DG, Staurenghi G, Henry EC, Brittain C. Clinical endpoints for the study of geographic atrophy secondary to AMD. Retina. 2016;36(10):1806-22.
- Wu Z, Ayton LN, Luu CD, Guymer RH. Longitudinal changes in microperimetry and low luminance visual acuity in AMD. JAMA Ophthalmol. 2015;133:442–48.
- Monés J, Rubin GS. Contrast sensitivity as an outcome measure in patients with subfoveal choroidal neovascularisation due to AMD. Eye (Lond). 2005;19(11):1142-50.
- Sunness JS, Rubin GS, Broman A, Applegate CA, Bressler NM, Hawkins BS. Low luminance visual dysfunction as a predictor of subsequent visual acuity loss from geographic atrophy in AMD. Ophthalmology. 2008 Sep;115(9):1480-8, 1488.e1-2.
- Kimel M, Leidy NK, Tschosik E, et al. Functional Reading Independence (FRI) Index: a new patient-reported outcome measure for patients with geographic atrophy. Invest Ophthalmol Vis Sci. 2016;57:6298-304.
EU-GA-2100012